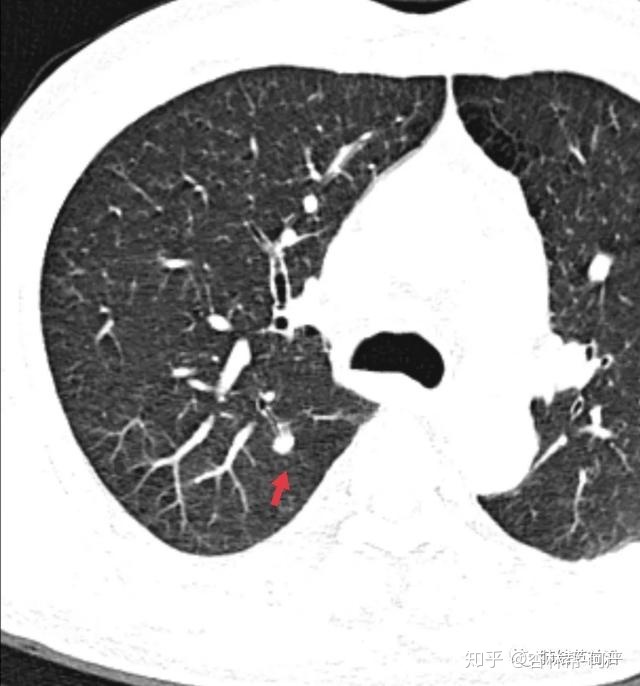
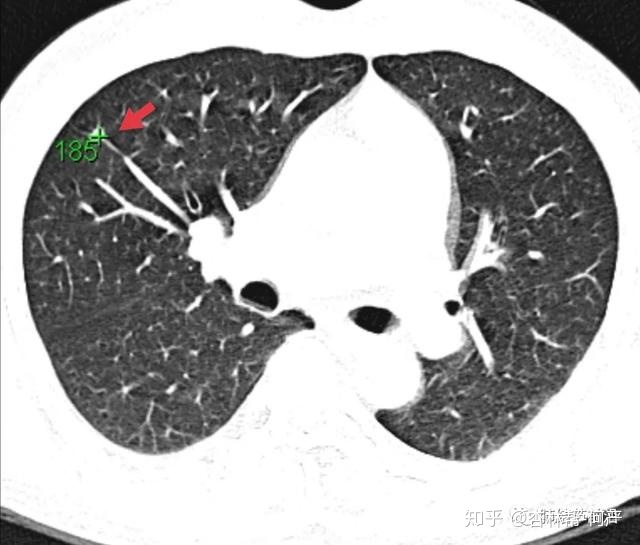

本文转自微信公众号:肺结节前沿
作者简介:张勇,复旦大学附属中山医院呼吸科副主任医师、博士。擅长肺部结节的人工智能(AI)良恶性鉴别、疑难肺部结节的鉴别诊断、肺部磨玻璃结节(GGN)的定性与分级(腺瘤增生-原位癌-微浸润-浸润性腺癌)、肺部磨玻璃结节的浸润风险评估,手术时机的选择、肺部结节的磁导航支气管镜活检及微创消融、肺部肿瘤的诊治(靶向,免疫,放化疗)。
CT值可以在薄层CT的DICOM原始图像文件中测得。CT值反应着结节的密度,在肺结节的诊断中意义很大,先看片。

结节1:7mm实性结节,边界光滑,CT图像大概率为良性结节。
结节2:8mm实性结节,边界稍毛糙,支气管进入,CT图像提示为肺癌可能。

结节3:8mm实性结节,长毛刺,三角形,为良性表现。但是有血管进入,能排除肺癌么?不敢。
对于这三个结节,我们测一下CT值,就会有极为牢固的诊断证据。
CT值得定义为,空气-1000,水为0,骨性组织为1000。CT值越高,则密度越高。而良性肺结节很多为慢性炎症,即纤维化结节(类似于皮肤上的外伤瘢痕)。纤维化结节的密度要大大高于肿瘤组织。有研究统计,肺结节的CT值超过167,基本考虑慢性炎症纤维化。为更保险起见,建议把诊断阈值定性为200,即肺结节密度均匀且CT值高于200。基本考虑良性纤维化结节,而不考虑肺癌。

结节1:CT值为197,诊断为纤维灶结节。

结节2:CT值为214,诊断为纤维灶结节。
结节3:CT值为185,诊断为良性纤维灶结节。
这三例结节测CT值后,均接近200或高于200。对于这样的结节,基本可以排除肺癌。可以放心随访,大大减轻患者的焦虑(随访的间期对很多人来说是极大的煎熬)。第一次3-6个月,以后6-12月复查,三年完全排除肺癌。
纤维灶有个例外,你就是结核瘢痕,有约1%的概率在结核瘢痕上发展成为肺癌。


这个右上肺结节CT值也很高>200,但是其周边出现了磨玻璃影,为贴壁样生长的肺癌。术后病理为:微浸润腺癌。因此,纤维灶附近出现边界清楚的磨玻璃影,也是需要警惕的。
本期Tips:
1.采用薄层CT测CT值,结节密度整体升高>200,基本考虑慢性炎症纤维化结节,是排除肺癌极为强烈的证据,可以明显减轻患者的焦虑。
2. 结核纤维瘢痕有小概率事件转化为肺癌,虽然密度也可能>200,但周边出现磨玻璃影,或者瘢痕增大,也要警惕肺癌。






















 1万+
1万+

 被折叠的 条评论
为什么被折叠?
被折叠的 条评论
为什么被折叠?








